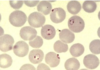

Eukaryote microbes lab exam Flashcards
(17 cards)

Budding yeast
- look for lots of pink dots
- if their is a chain of yeast it is (pseudohypha)

Rhizopus (full structure)
- reproductive hyphae( the stick pat of lollipop)
- Sporangium ( the head of the lollipop where spores are made)

Rhizopus
- sporangiospores( spores leaving)
- reproductive hyphae ( stick of the lollipop)

Penicillium
- Condiospore ( spores coming off top of penicillium)
- branch( one of 2-4 sections at top of penicillium)
- condiophore ( reproductive hypa, note these are made of multiple cells)



Aspergillus
look for brown/ on black media
speckled with white dots

Rhizopus
look for white cloudy looking with black spots

Penicillium
look for white soft pillow.. Not no dots appear, no Sporangiospores

enterobius vermicularis
A pin worm. Lives in large intestine. Get it from contact or fecal oral

Trichinella spiralis cycst
round worm found in the muscle tissue of infected carnivores.
get it from not eating fully cooked meat (especially pork and wild animals)

Trichomonas vaginalis
group: Mastigiophora (flagellates)
reserviour: infected reproductive track
transmistion: direct contact normally STD
polymorphic: no
MN, could u get it? Yes this is very common
what is tested for diagnosis? Overnight culture of a cervical smear
symptoms? In men often a symptomatic, in women like a UTI
Plasmodium sp.
- group: apicomlexa ( complex life cycle)
- reservoir: infected blood and mosquitos
- transmitted: Anopholis mosquitos
- why hard to diagnose?
- use of prophalatics to prevent disease
- pt profile? Fever, headache, travil to location with malaria 2 weeks prior
- malaria is not in Mn becuase mosquitos that carry it are not here
- could get it if I go to tropical location
- test for diagnosis: blood draw

Giardia lamblia
- cyst: line down the middle
- trophozite: teardrop shaped and has two eyes
- group: mastigophora ( flagella)
- resiviour: gut of vertebrates
- transmition: fecal oral
- there is a low LD50 so it can be hard to diagnose
- symptoms: diarrhea, cramping, fluid loss, weight loss
- you can get it in MN
- Still sample is used for diagnosis


Trypanosoma cruzi aka chaga’s disease
- group: mastigophora ( flagella)
- resivoir: ruduvid insect
- transmitted: bite of infected reduvid insect, or blood transfusion
- Often misdiagnosed as heart problem because medical personal are unaware of protozoan connection (often a symptomatic early in infection)
- symptoms: fever, fatigue, cardiac arithmia, loss of appetite, diarrhea, vomitting
- you can Not get it in MN, only by travil to South or central America
- Blood sample is used for diagnosis to look for antibodies.


Leishmania sp.
- group: mastigophora (Flagella)
- resivour: rat, fleas, humans
- transmitted: bite of infected sand flea
- hard to diagnose: symptoms can appear years after infection
- pt profile: fever, wt. loss, low RBC or WBC, enlarged spleen or liver
- pt profile: could have skin sores
- not in Mn only through travel to
- lots of different ways but antibodies in blood is one way.
Naegleria fowleri
Brain amoeba
- Group: sarcodina (amoebas)
- reservior: warm water no salt
- tranmition: through nose while swimming in infected water
- why hard to diagnose:( guess is LD50 is small)
- pt profile: nerual symptoms, often fatal, headache, vomiting, diarrhea
- in MN: yes a boy died in Stillwater from this
- what is used to detect: spinal tap or Ct/MRI of brain
*

Toxoplasma gondii
- group: apicomplexa
- reservior:
- transmitted: food exposure of infected meet, exposure to fecal matter of infected cats
- hard to Id? Often peps are asymptomatic
- pt profile: people feel like they have flu,
- in Mn: yes
- dignosis confermed by blood seriology
- why should pregnant women a aid cat litter? The disease does not kill adults but devastating to fetuses or immune compromised